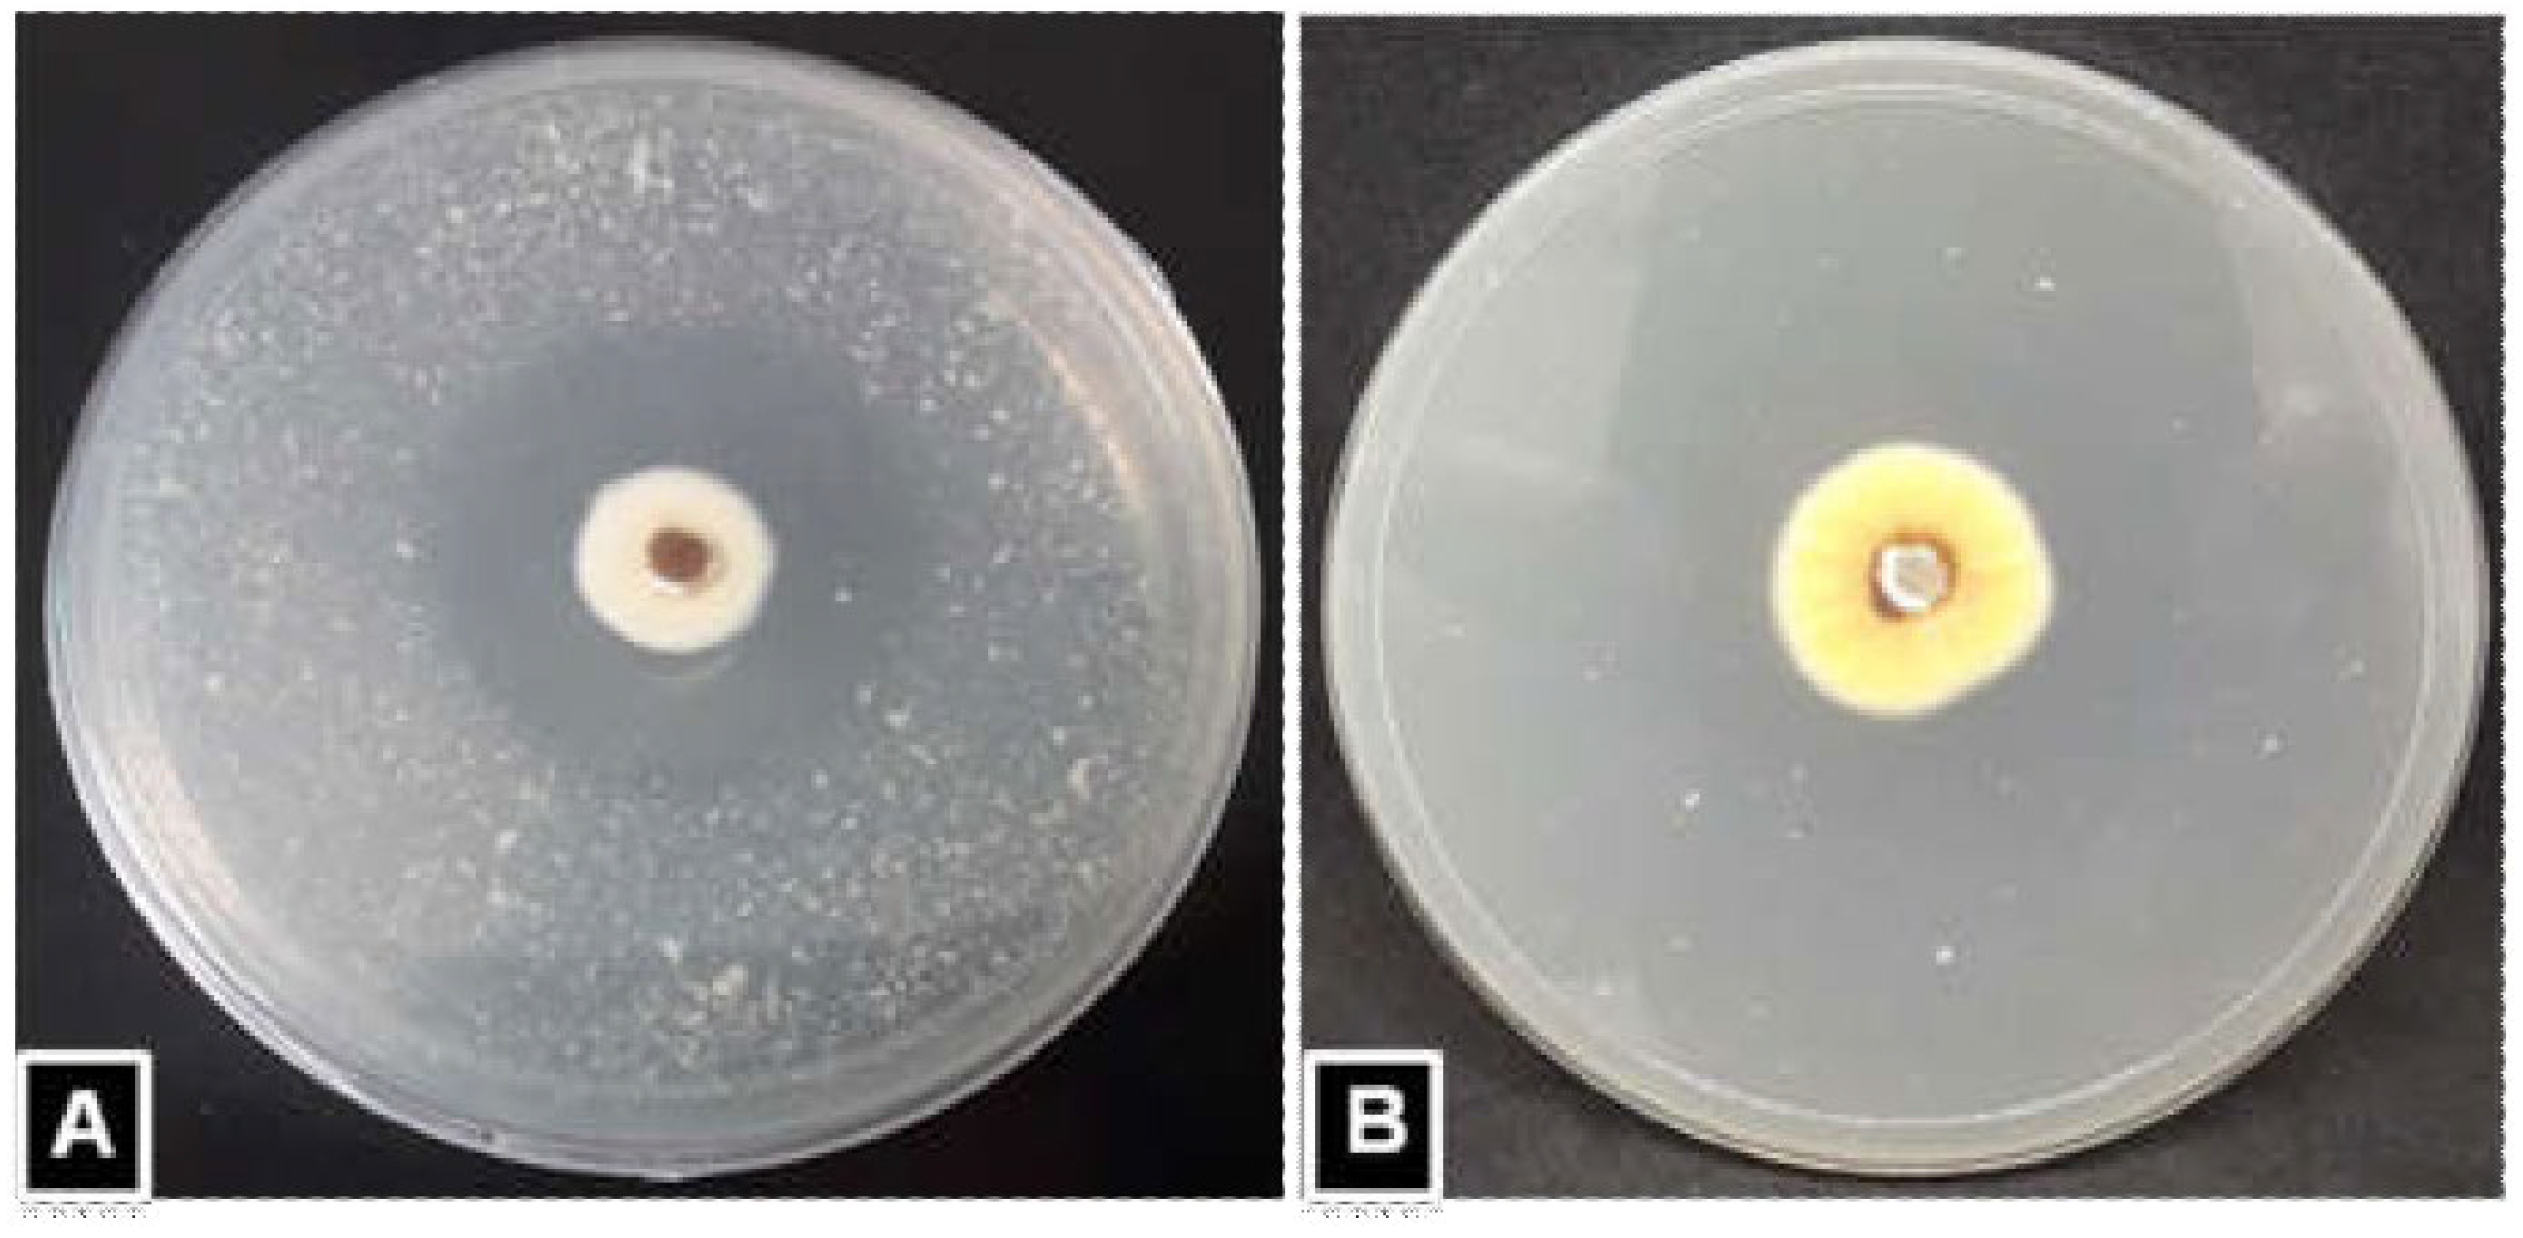
Horticulturae 08 00808 g001

Field Efficacy of Proteolytic Entomopathogenic Fungi against Ceratovacuna lanigera Zehntner
Abstract
1. Introduction
2. Materials and Methods
2.1. Fungi Isolates
2.2. Preparation of Skimmed Milk Agar Medium
2.3. Protease Assay
2.4. Colony Growth Rate and Sporulation
2.5. Identification of Fungi
2.6. Phylogenetic Analysis
2.7. Determination of Lethal Concentrations and Lethal Times in Laboratory Bioassay
2.8. Field Experimental Plots
2.9. Preparation of Conidial Formulation
2.10. Application of Formulation
2.11. Aphid Counts
2.12. Persistence Assessment of Conidia on Leaves
2.12.1. Leaf Collection and Preparation
2.12.2. Recovery of Conidia and Quantification of CFUs
2.12.3. Calculation of the Reduction (%) of Conidia from Leaves
2.13. Assessment of Impact of EPF Application on Yield Components and Sugar Content
2.13.1. Length and Width of Leaf
2.13.2. Height and Girth of Sugarcane
2.13.3. Weight of Cane and Sugar Content
2.14. Statistical Analysis
3. Results
3.1. Proteolytic Fungi Isolates
3.2. Colony Growth Rate and Sporulation
3.3. Morphological Characterization

3.4. Molecular Identification
3.5. Phylogenetic Analysis
3.6. Lethal Concentrations and Lethal Times for the Isolates
3.7. Efficacy of EPF for Controlling C. lanigera in Field Conditions
3.8. Persistence of Fungi Conidia on Sugarcane Leaves
3.9. Impact of EPF Application on Yield Component and Sugar Content
4. Discussion
5. Conclusions
Author Contributions
Funding
Institutional Review Board Statement
Informed Consent Statement
Data Availability Statement
Acknowledgments
Conflicts of Interest
References
- Mukunthan, N.; Srikanth, J.; Singaravelu, B.; Asokan, S.; Kurup, N.K.; Goud, Y.S. Assessment of woolly aphid impact on growth, yield and quality parameters of sugarcane. Sugar Tech. 2008, 10, 143–149. [Google Scholar] [CrossRef]
- Usman, M.; Wakil, W.; Piñero, J.C.; Wu, S.; Toews, M.D.; Shapiro-Ilan, D.I. Evaluation of Locally Isolated Entomopathogenic Fungi against Multiple Life Stages of Bactrocera zonata and Bactrocera dorsalis (Diptera: Tephritidae): Laboratory and Field Study. Microorganisms 2021, 9, 1791. [Google Scholar] [CrossRef]
- Du, D.; Lu, L.; Hu, X.; Pu, Z.; Huang, Z.; Chen, G.; Liu, S.; Lyu, J. Virulence of Purpureocillium lilacinum strain ZJPL08 and efficacy of a wettable powder formulation against the Asian citrus psyllid (Diaphorina citri). Biotechnol. Biotechnol. Equip. 2020, 34, 1104–1113. [Google Scholar] [CrossRef]
- Mustafa, U.; Kaur, G. Extracellular Enzyme Production in Metarhizium anisopliae Isolates. Folia Microbiol. 2009, 54, 499–504. [Google Scholar] [CrossRef] [PubMed]
- Clarkson, J.M.; Charnley, A.K. New insights into the mechanisms of fungal insect pathogenesis in insects. Trends Microbiol. 1996, 4, 197–203. [Google Scholar] [CrossRef]
- Khan, S.; Nadir, S.; Wang, X.; Khan, A.; Xu, J.; Li, M.; Tao, L.; Karunarathna, S.C. Using in silico techniques: Isolation and characterization of an insect cuticle-degrading-protease gene from Beauveria bassiana. Microb. Pathog. 2016, 97, 189–197. [Google Scholar]
- Zhang, Y.J.; Feng, M.G.; Fan, Y.H.; Luo, Z.B.; Yang, X.Y.; Wu, D.; Pei, Y. A cuticle-degrading protease (CDEP-1) of Beauveria bassiana enhances virulence. Biocontrol Sci. Technol. 2008, 18, 543–555. [Google Scholar] [CrossRef]
- Inglis, G.D.; Goettel, M.S.; Johnson, D.L. Persistence of the entomopathogenic fungus, Beauveria bassiana, on phylloplanes of crested wheatgrass and alfalfa. Biol. Control 1993, 3, 258–270. [Google Scholar] [CrossRef][Green Version]
- Jaronski, S.T. Ecological factors in the inundative use of fungal entomopathogens. BioControl 2010, 55, 159–185. [Google Scholar] [CrossRef]
- Sayed, S.M.; Ali, E.F.; Al-Otaibi, S.S. Efficacy of indigenous entomopathogenic fungus, Beauveria bassiana (Balsamo) Vuillemin, isolates against the rose aphid, Macrosiphum rosae L. (Hemiptera: Aphididae) in rose production. Egypt. J. Biol. Pest Control 2019, 29, 19. [Google Scholar] [CrossRef]
- Ramanujam, B.; Japur, K.; Poornesha, B. Field Efficacy of Entomopathogenic Fungi against Brinjal and Chilli Aphid (Aphis gossypii Glover) (Homoptera: Aphididae). Pestic. Res. J. 2018, 30, 159–162. [Google Scholar] [CrossRef]
- Dokki, E.T.S.; Cairo, E. Efficacy of two entomopathogenic fungi against corn pests under laboratory and field conditions in Egypt. Europ. J. Acad. Essays. 2014, 1, 1–6. [Google Scholar]
- Mendoza, A.R.; Sikora, R.A.; Kiewnick, S. Influence of Paecilomyces lilacinus strain 251 on the biological control of the burrowing nematode Radopholus similis in bananas. Nematropica 2007, 203–214. [Google Scholar]
- Roumpos, C. Ecological Studies on Praecilomyces Lilacinus Strain 251 and Their Importance for Biocontrol of Plant-Parasitic Nematodes and Environmental Risk Assessment; Cuvillier Verlag: Gottingen, Germany, 2006; pp. 1–8. [Google Scholar]
- Amala, U.; Jiji, T.; Naseema, A. Laboratory evaluation of local isolate of entomopathogenic fungus, Paecilomyces lilacinus Thom Samson (ITCC 6064) against adults of melon fruit fly, Bactrocera cucurbitae Coquillett. J. Trop. Agric. 2013, 51, 132–134. [Google Scholar]
- Luz, C.; Tai, M.H.H.; Santos, A.H.; Rocha, L.F.N.; Albernaz, D.A.S.; Silva, H.H.G. Ovicidal activity of entomopathogenic hyphomycetes on Aedes aegypti (Diptera: Culicidae) under laboratory conditions. J. Med. Entomol. 2007, 44, 799–804. [Google Scholar] [CrossRef] [PubMed]
- Goffré, D.; Folgarait, P.J. Purpureocillium lilacinum, potential agent for biological control of the leaf-cutting ant Acromyrmex lundii. J. Invertebr. Pathol. 2015, 130, 107–115. [Google Scholar] [CrossRef]
- Fernandes, E.G.; Valério, H.M.; Borges, M.A.Z.; Mascarin, G.M.; Silva, C.E.; Van Der Sand, S.T. Selection of fungi for the control of Musca domestica in aviaries. Biocontol. Sci. Tech. 2013, 23, 1256–1266. [Google Scholar] [CrossRef]
- Gökçe, A.; Er, M.K. Pathogenicity of Paecilomyces spp. to the glasshouse whitefly, Trialeurodes vaporariorum, with some observations on the fungal infection process. Turk. J. Agric. For. 2005, 29, 331–340. [Google Scholar]
- Fiedler, Ż.; Sosnowska, D. Nematophagous fungus Paecilomyces lilacinus (Thom) Samson is also a biological agent for control of greenhouse insects and mite pests. BioContol. 2007, 52, 547–558. [Google Scholar] [CrossRef]
- Rambadan, S.; Jugmohan, H.; Khan, A. Pathogenicity and haemolymph protein changes in Edessa meditabunda F. (Hemiptera: Pentatomidae) infected by Paecilomyces lilacinus. J. Biopestic. 2011, 4, 169. [Google Scholar]
- Lopez, D.C.; Zhu-Salzman, K.; Ek-Ramos, M.J.; Sword, G.A. The entomopathogenic fungal endophytes Purpureocillium lilacinum (formerly Paecilomyces lilacinus) and Beauveria bassiana negatively affect cotton aphid reproduction under both greenhouse and field conditions. PLoS ONE 2014, 9, e103891. [Google Scholar]
- Kepenekci, İ.; Yesilayer, A.; Atay, T.; Tulek, A. Pathogenicity of the entomopathogenic fungus, Purpureocillium lilacinum TR1 against the Black Cherry Aphid, Myzus cerasi Fabricus (Hemiptera: Aphididae). Munis Entomol. Zool. 2014, 10, 53–60. [Google Scholar]
- Toledo-Hernández, R.A.; Toledo, J.; Valle-Mora, J.; Holguín-Meléndez, F.; Liedo, P.; Huerta-Palacios, G. Pathogenicity and virulence of Purpureocillium lilacinum (Hypocreales: Ophiocordycipitaceae) on Mexican fruit fly adults. Fla. Entomol. 2019, 102, 309–314. [Google Scholar] [CrossRef]
- Liu, Z.; Liu, F.F.; Li, H.; Zhang, W.T.; Wang, Q.; Zhang, B.X.; Sun, Y.X.; Rao, X.J. Virulence of the Bio-Control Fungus Purpureocillium lilacinum against Myzus persicae (Hemiptera: Aphididae) and Spodoptera frugiperda (Lepidoptera: Noctuidae). J. Econ. Entomol. 2022, 115, 462–473. [Google Scholar] [CrossRef]
- Medeiros, F.R.; Lemos, R.N.S.D.; Rodrigues, A.A.C.; Batista Filho, A.; Oliveira, L.D.J.M.G.D.; Araújo, J.R.G. Occurrence of Purpureocillium lilacinum in citrus black fly nymphs. Rev. Bras. 2018, 40, 1–3. [Google Scholar] [CrossRef]
- Demirci SN, Ş.; Altuntaş, H. Entomopathogenic potential of Purpureocillium lilacinum against the model insect Galleria mellonella (Lepidoptera: Pyralidae). Environ. Exp. Biol. 2019, 17, 71–74. [Google Scholar]
- Siddiquee, S. Practical Handbook of the Biology and Molecular Diversity of Trichoderma Species from Tropical Regions; Springer International Publishing: Cham, Switzerland, 2017; p. 22. [Google Scholar]
- Mohanasrinivasan, V.; Vani, S.; Raisha, E.; Soumya, A.R.; Devi, C.S. Isolation, screening and identification of protease producing fungi from rhizosphere soil and optimisation of pH, incubation time and inducer concentration for enhanced protease production. Int. J. Pharm. Bio. Sci. 2012, 3, B784–B793. [Google Scholar]
- Abe, C.A.L.; Faria, C.B.; De Castro, F.F.; De Souza, S.R.; Santos, F.C.D.; Da Silva, C.N.; Tessmann, D.J.; Barbosa-Tessmann, I.P. Fungi isolated from maize (Zea mays L.) grains and production of associated enzyme activities. Int. J. Mol. Sci. 2015, 16, 15328–15346. [Google Scholar] [CrossRef] [PubMed]
- Hossain, M.I.; Ahmad, K.; Vadamalai, G.; Siddiqui, Y.; Saad, N.; Ahmed, O.H.; Hata, E.M.; Adzmi, F.; Rashed, O.; Rahman, M.Z.; et al. Phylogenetic analysis and genetic diversity of Colletotrichum falcatum isolates causing sugarcane red rot disease in Bangladesh. Biology 2021, 10, 862. [Google Scholar] [CrossRef]
- Nouri Aiin, M.; Askary, H.; Imani, S.; Zare, R. Isolation and characterization of entomopathogenic fungi from hibernating sites of Sunn Pest (Eurygaster integriceps) on Ilam Mountains, Iran. Int. J. Curr. Microbiol. Appl. Sci. 2014, 3, 314–325. [Google Scholar]
- Luangsa-Ard, J.J.; Houbraken, T.; van Doorn, S.B.; Hong, A.M.; Borman, N.L.; Hywel-Jones, N.; Samson, R.A. Purpureocillium, a new genus for the medically important Paecilomyces lilacinus. FEMS Microbiol. Lett. 2011, 321, 141–149. [Google Scholar] [CrossRef] [PubMed]
- Cubero, O.F.; Crespo, A.N.A.; Fatehi, J.; Bridge, P.D. DNA extraction and PCR amplification method suitable for fresh, herbarium-stored, lichenized, and other fungi. Pl. Syst. Evol. 1999, 216, 243–249. [Google Scholar] [CrossRef]
- White, T.J.; Bruns, T.; Lee, S.J.W.T.; Taylor, J. Amplification and direct sequencing of fungal ribosomal RNA genes for phylogenetics. In PCR Protocols: A Guide to Methods and Applications; Academic Press: Cambridge, MA, USA, 1990; Volume 18, pp. 315–322. [Google Scholar]
- Castillo, M.G.; Rivera, I.A.; Padilla, A.B.; Lara, F.; Victoriano, C.N.; Herrera, R.R. Isolation and identification of novel entomopathogenic fungal strains of the Beauveria and Metarhizium generous. BioTechnol. Indian J. 2012, 6, 386–395. [Google Scholar]
- Kumar, S.; Stecher, G.; Li, M.; Knyaz, C.; Tamura, K. MEGA X: Molecular Evolutionary Genetics Analysis across computing platforms. Mol. Biol. Evol. 2018, 35, 1547–1549. [Google Scholar] [CrossRef]
- Sneath, P.H.A.; Sokal, R.R. Numerical Taxonomy; Freeman: San Francisco, CA, USA, 1973. [Google Scholar]
- Kimura, M. A simple method for estimating evolutionary rate of base substitutions through comparative studies of nucleotide sequences. J. Mol. Evol. 1980, 16, 111–120. [Google Scholar] [CrossRef]
- Naik, P.H. Field evaluation of different entomopathogenic fungal formulations against sucking pests of okra. Karnataka J. Agril. Sci. 2009, 22, 575–578. [Google Scholar]
- Ujjan, A.A.; Shahzad, S. Use of entomopathogenic fungi for the control of mustard aphid (Lipaphis erysimi) on canola (Brassica napus L.). Pak. J. Bot. 2012, 44, 2081–2086. [Google Scholar]
- Harris-Shultz, K.; Knoll, J.; Punnuri, S.; Niland, E.; Ni, X. Evaluation of strains of Beauveria bassiana and Isaria fumosorosea to control sugarcane aphids on grain sorghum. Agrosyst. Geosci. Environ. 2020, 3, e20047. [Google Scholar] [CrossRef]
- Abbott, W.S. A method of computing the effectiveness of an insecticide. J. Am. Mosq. Control Assoc. 1987, 3, 302–303. [Google Scholar] [CrossRef]
- Shrestha, G.; Enkegaard, A.; Steenberg, T. Laboratory and semi-field evaluation of Beauveria bassiana (Ascomycota: Hypocreales) against the lettuce aphid, Nasonovia ribisnigri (Hemiptera: Aphididae). Biol. Control 2015, 85, 37–45. [Google Scholar] [CrossRef]
- Gatarayiha, M.C.; Laing, M.D.; Miller, R.M. Effects of crop type on persistence and control efficacy of Beauveria bassiana against the two spotted spider mite. BioControl 2010, 55, 767–776. [Google Scholar] [CrossRef]
- Donga, T.K.; Vega, F.E.; Klingen, I. Establishment of the fungal entomopathogen Beauveria bassiana as an endophyte in sugarcane, Saccharum officinarum. Fungal Ecol. 2018, 35, 70–77. [Google Scholar] [CrossRef]
- Banasihan, V.T.; Macalaguim, V.V.; Mendoza, T.C. Glyphosate as a ripener in sugarcane production in Batangas. Philipp. J. Crop Sci. 2007, 32, 31–45. [Google Scholar]
- Finney, D.J. Probit Analysis; Cambridge University Press: Cambridge, UK, 1952. [Google Scholar]
- Mukherjee, A.; Debnath, P.; Ghosh, S.K.; Medda, P.K. Biological control of papaya aphid (Aphis gossypii Glover) using entomopathogenic fungi. Vegetos 2020, 33, 1–10. [Google Scholar] [CrossRef]
- Inglis, G.D.; Enkerli, J.; Goettel, M.S. Laboratory techniques used for entomopathogenic fungi: Hypocreales. Man. Tech. Invertebr. Pathol. 2012, 2, 18–53. [Google Scholar]
- Bai, N.S.; Remadevi, O.K.; Sasidharan, T.O.; Balachander, M.; Dharmarajan, P. Cuticle degrading enzyme production by some isolates of the entomopathogenic fungus, Metarhizium anisopliae (Metsch.). J. Bio Sci. 2012, 20, 25–32. [Google Scholar] [CrossRef]
- Nawar, M.A.; Abo-Elnasr, A.A.; Kobisi, A.N.A.; Hefnawy, G.A. Evaluation of acaricidal activity of Purpureocillium lilacinum isolated from Egyptian soil against Tetranychus urticae. Egypt. J. Des. Res. 2018, 68, 157–172. [Google Scholar] [CrossRef]
- Schuster, F.P.W.; Maffessoni, C.; de Angelis, D.A.; Giachini, A.J.; Cardoso, D.H.; Moroni, L.S.; Skoronski, E.; Kempka, A.P. Screening and evaluation of filamentous fungi potential for protease production in swine plasma and red blood cells-based media: Qualitative and quantitative methods. Biocat. Agril. Biotech. 2019, 21, 101313. [Google Scholar] [CrossRef]
- Ariffin, Z.Z.; Ahmad, M.S.; Pepi, R.; Noor, Z.M. Proteolytic fungi from virgin forest. J. Teknol. 2016, 78, 37–41. [Google Scholar]
- Anilkumar, R.R.; Pradeep, N.S. Screening and Identification of halotolerant protease producing fungi from mangrove sediments of Kerala. Int. J. Biotechnol. Biochem. 2017, 13, 237–252. [Google Scholar]
- Valadares-Inglis, M.C.; Azevedo, J.L. Amylase and protease secretion in recombinant strains of Metarhizium anisopliae var anisopliae following parasexual crosses. Braz. J. Gene. 1997, 20, 171–175. [Google Scholar]
- Dias, B.A.; Neves, P.M.O.J.; Furlaneto-Maia, L.; Furlaneto, M.C. Cuticle-degrading proteases produced by the entomopathogenic fungus Beauveria bassiana in the presence ofcoffee berry borer cuticle. Braz. J. Microbiol. 2008, 39, 301–306. [Google Scholar] [CrossRef]
- Dhawan, M.; Joshi, N. Enzymatic comparison and mortality of Beauveria bassiana against cabbage caterpillar Pieris brassicae LINN. Braz. J. Microbiol. 2017, 48, 522–529. [Google Scholar] [CrossRef]
- Bidochka, M.J.; Khachatourians, G.G. Identification of Beauveria bassiana extracellular protease as a virulence factor in pathogenicity toward the migratory grasshopper, Melanoplus sanguinipes. J. Invertbr. Pathol. 1990, 56, 362–370. [Google Scholar] [CrossRef]
- Perinotto, W.M.; Golo, P.S.; Rodrigues, C.J.C.; Sá, F.A.; Santi, L.; da Silva, W.O.B.; Junges, A.; Vainstein, M.H.; Schrank, A.; Salles, C.M.; et al. Enzymatic activities and effects of mycovirus infection on the virulence of Metarhizium anisopliae in Rhipicephalus microplus. Veteri. Parasitol. 2014, 203, 189–196. [Google Scholar] [CrossRef] [PubMed]
- Inglis, G.D.; Ivie, T.J.; Duke, G.M.; Goettel, M.S. Influence of rain and conidial formulation on persistence of Beauveria bassiana on potato leaves and Colorado potato beetle larvae. Biol. Control 2000, 18, 55–64. [Google Scholar] [CrossRef]
- Alves, R.T.; Bateman, R.P.; Prior, C.; Leather, S.R. Effects of simulated solar radiation on conidial germination of Metarhizium anisopliae in different formulations. Crop Protect. 1998, 17, 675–679. [Google Scholar] [CrossRef]
- Ibrahim, L.; Butt, T.M.; Beckett, A.; Clark, S.J. The germination of oil-formulated conidia of the insect pathogen, Metarhizium anisopliae. Mycol. Res. 1999, 103, 901–907. [Google Scholar] [CrossRef]
- Michereff Filho, M.; Oliveira, S.O.D.; De Liz, R.S.; Faria, M. Cage and field assessments of Beauveria bassiana-based Mycoinsecticides for Myzus persicae Sulzer (Hemiptera: Aphididae) control in cabbage. Neotrop. Entomol. 2011, 40, 470–476. [Google Scholar]
- Hatting, J.L.; Wraight, S.P.; Miller, R.M. Efficacy of Beauveria bassiana (Hyphomycetes) for control of Russian wheat aphid (Homoptera: Aphididae) on resistant wheat under field conditions. Biocontrol Sci. Technol. 2004, 14, 459–473. [Google Scholar] [CrossRef]
- Wawdhane, P.A.; Nandanwar, V.N.; Mahankuda, B.; Ingle, A.S.; Chaple, K.I. Bio-efficacy of insecticides and bio pesticides against major sucking pests of Bt-cotton. J. Entomol. Zoo. Study 2020, 8, 829–833. [Google Scholar]
- Castrillo, L.A.; Griggs, M.H.; Liu, H.; Bauer, L.S.; Vandenberg, J.D. Assessing deposition and persistence of Beauveria bassiana GHA (Ascomycota: Hypocreales) applied for control of the emerald ash borer, Agrilus planipennis (Coleoptera: Buprestidae), in a commercial tree nursery. Biol. Control 2010, 54, 61–67. [Google Scholar] [CrossRef]
- Kouassi, M.; Coderre, D.; Todorova, S.I. Effect of plant type on the persistence of Beauveria bassiana. Biocontrol Sci. Technol. 2003, 13, 415–427. [Google Scholar] [CrossRef]
- Ignoffo, C.M. Environmental factors affecting persistence of entomopathogens. Fla. Entomol. 1992, 75, 516–525. [Google Scholar] [CrossRef]
- Singh, P.; Dhal, M.K.; Sagar, S.K. Experimental investigation on nutritional variation in plant foliage of rose (Rosa damascene): Effect of pest infestation. Int. J. Sci. Res. Publ. 2014, 4, 1–12. [Google Scholar]
- Kishore Varma, P.; Chandra Sekhar, V.; Bhavani, B.; Upendhar, S. Cladosporium cladosporioides: A new report of parasitism on sugarcane woolly aphid, Ceratovacuna lanigera Zehntner. J. Entomol. Zoolog. Stud. 2019, 7, 1122–1126. [Google Scholar]
- Patil, A.S.; Magar, S.B.; Shinde, V.D. Biological control of the sugarcane Woolly Aphid (Ceratovacuna lanigera) in Indian sugarcane through the release of predators. In Proceedings of the XXVI Congress, International Society of Sugar Cane Technologists, ICC, Durban, South Africa, 29 July–2 August 2007; International Society Sugar Cane Technologists (ISSCT): Réduit, Mauritius, 2007; pp. 797–804. [Google Scholar]
- Raya-Díaz, S.; Sánchez-Rodríguez, A.R.; Segura-Fernández, J.M.; Del Campillo, M.D.C.; Quesada-Moraga, E. Entomopathogenic fungi-based mechanisms for improved Fe nutrition in sorghum plants grown on calcareous substrates. PLoS ONE 2017, 12, e0185903. [Google Scholar] [CrossRef]
- Dara, S.K.; Dara, S.S.; Dara, S.S. Impact of entomopathogenic fungi on the growth, development, and health of cabbage growing under water stress. Am. J. Plant Sci. 2017, 8, 1224. [Google Scholar] [CrossRef]

| Isolates | Diameter (mm) of Degradation Zone (R) (Diameter of Clear Zone + Diameter of Colony) | Diameter (mm) of Colony (r) | Enzyme Index (EI) = Diameter of Degradation Zone(R)/Diameter of Colony (r) | ||||||
|---|---|---|---|---|---|---|---|---|---|
| Incubation Periods | Incubation Periods | Incubation Periods | |||||||
| 24 h | 48 h | 72 h | 24 h | 48 h | 72 h | 24 h | 48 h | 72 h | |
| PLMS4 | 16.00 ± 1.00 bcd | 25.00 ± 1.00 cd | 30.00 ± 1.00 def | 7.33 ± 0.58 ab | 10.00 ± 1.00 ab | 16.66 ± 0.58 ab | 2.18 ± 0.2 cd | 2.50 ± 0.15 bcd | 1.79 ± 0.03 efg |
| PLTP5 | 18.66 ± 0.58 a | 27.33 ± 0.58 a | 34.00 ± 1.00 a | 6.66 ± 0.58 b | 9.33 ± 0.58 b | 15.00 ± 1.00 c | 2.80 ± 0.17 a | 2.93 ± 0.21 a | 2.29 ± 0.06 a |
| PLKM7 | 16.66 ± 0.58 bc | 26.66 ± 1.53 abc | 30.66 ± 0.58 bcde | 7.33 ± 0.58 ab | 10.33 ± 1.15 ab | 16.33 ± 0.58 abc | 2.31 ± 0.09 bcd | 2.58 ± 0.17 bcd | 1.87 ± 0.06 de |
| PLPS8 | 17.33 ± 0.58 ab | 26.33 ± 0.58 abc | 32.33 ± 1.53 ab | 6.66± 0.58 b | 9.66 ± 0.58 ab | 15.33 ± 0.58 bc | 2.60 ± 0.21 ab | 2.73 ± 0.13 ab | 2.10 ± 0.04 b |
| PLMS9 | 15.00 ± 1.00 d | 24.00 ± 1.00 d | 28.00 ± 1.00 g | 7.33 ± 0.58 ab | 10.66 ± 0.58 ab | 16.66 ± 0.58 ab | 2.04 ± 0.19 cd | 2.25 ± 0.24 d | 1.68 ± 0.13 g |
| PLMC11 | 17.00 ± 1.00 bc | 27.00 ± 1.00 ab | 32.00 ± 1.00 bc | 7.00 ± 1.00 ab | 10.00 ± 1.00 ab | 15.66 ± 0.58 abc | 2.45 ± 0.33 abc | 2.70 ± 0.17 abc | 2.04 ± 0.03 bc |
| PLMS12 | 16.33 ± 0.58 bcd | 26.33 ± 1.15 abc | 30.33 ± 1.15 cdef | 7.33 ± 0.58 ab | 10.33 ± 0.58 ab | 16.33 ± 0.58 abc | 2.23 ± 0.2 cd | 2.55 ± 0.13 bcd | 1.85 ± 0.07 def |
| PLMS44 | 15.66 ± 1.15 cd | 25.33 ± 1.15 bcd | 29.00 ± 1.00 efg | 7.00 ± 1.00 ab | 10.33 ± 0.58 ab | 16.66 ± 1.53 ab | 2.16 ± 0.25 cd | 2.45 ± 0.13 bcd | 1.74 ± 0.11 efg |
| PLMS88 | 15.00 ± 1.00 d | 25.33 ± 0.58 bcd | 28.66 ± 0.58 fg | 8.33 ± 0.60 a | 11.00 ± 1.00 a | 17.00 ± 1.00 a | 1.80 ± 0.21 d | 2.30 ± 0.33 cd | 1.69 ± 0.13 g |
| PLMS113 | 16.66 ± 1.53 bc | 26.33± 1.15 abc | 31.00 ± 1.00 bcd | 7.00 ± 1.00 ab | 10.00 ± 1.00 ab | 16.33 ± 1.00 abc | 2.39 ± 0.13 bcd | 2.60 ± 0.16 bcd | 1.89 ± 0.06 cd |
| LSD (0.05) | 1.61 | 1.73 | 1.75 | 1.35 | 1.52 | 1.55 | 0.35 | 0.32 | 0.13 |
| Isolates | Colony Growth Rate/Day (mm) | Spore Density (×108 Spore mL−1) |
|---|---|---|
| PLMS4 | 5.46 ± 0.17 bc | 3.37 ± 0.31 c |
| PLTP5 | 4.59 ± 0.31 f | 3.78 ± 0.19 bc |
| PLKM7 | 5.33 ± 0.13 bcd | 3.56 ± 0.28 c |
| PLPS8 | 4.86 ± 0.20 ef | 3.68 ± 0.14 bc |
| PLMS9 | 5.66 ± 0.17 ab | 4.17 ± 0.30 ab |
| PLMC11 | 5.02 ± 0.17 de | 3.64 ± 0.23 c |
| PLMS12 | 5.37 ± 0.20 bc | 3.49 ± 0.25 c |
| PLMS44 | 5.51 ± 0.25 abc | 3.42 ± 0.30 c |
| PLMS88 | 5.84 ± 0.17 a | 4.45 ± 0.20 a |
| PLMS113 | 5.17 ± 0.17 cde | 3.61 ± 0.13 c |
| LSD (0.05) | 0.34 | 0.50 |
| Isolates | Species of Fungi | Percentage of Identity | GenBank Accession Number | Crops | Locations |
|---|---|---|---|---|---|
| PLMS4 | P. lilacinum | 100.00 | MT529673.1 | Brinjal | Menggatal |
| PLTP5 | P. lilacinum | 99.36 | MK952567.1 | Pumpkin | Tuaran |
| PLKM7 | P. lilacinum | 100.00 | MK724002.1 | Maize | Kotabelud |
| PLPS8 | P. lilacinum | 100.00 | MT529673.1 | Sugarcane | Papar |
| PLMS9 | P. lilacinum | 99.57 | KJ191566.1 | Brinjal | Penampang |
| PLMC11 | P. lilacinum | 98.86 | KJ191566.1 | Mustard | Putatan |
| PLMS12 | P. lilacinum | 99.37 | MN962646.1 | Okra | Kotabelud |
| PLMS44 | P. lilacinum | 100.00 | MZ151176.1 | Okra | Penampang |
| PLMS88 | P. lilacinum | 100.00 | MZ290901.1 | Mustard | Menggatal |
| PLMS113 | P. lilacinum | 98.08 | MG748677.1 | Sugarcane | Putatan |
| Isolates | Conidia Conc. (Conidia mL−1) | Mortality (%) after 6 Days. | Log10 of Conidia Conc. | Probit Mortality | Regression Statistics, a = slope b = intercept | Regression Equation, Y = aX + b | LC50 (in LC50 Calculation, Y = 5, LC50 = antilogX) | LC90 (in LC90 Calculation, Y = 6.28, LC90 = antilogX) |
|---|---|---|---|---|---|---|---|---|
| PLMS4 | 1 × 105 | 40.25 | 5 | 4.75 | a = 0.311 b = 3.186 | Y = 0.311X + 3.186 | 6.76 × 105 | 8.87 × 109 |
| 1 × 106 | 50.00 | 6 | 5.00 | |||||
| 1 × 107 | 67.34 | 7 | 5.44 | |||||
| 1 × 108 | 74.49 | 8 | 5.64 | |||||
| PLTP5 | 1 × 105 | 52.52 | 5 | 5.08 | a = 0.375 b = 3.155 | Y = 0.375X + 3.155 | 8.31 × 104 | 2.13 × 108 |
| 1 × 106 | 60.67 | 6 | 5.28 | |||||
| 1 × 107 | 81.01 | 7 | 5.88 | |||||
| 1 × 108 | 87.26 | 8 | 6.13 | |||||
| PLKM7 | 1 × 105 | 41.10 | 5 | 4.77 | a = 0.336 b = 3.081 | Y = 0.336X + 3.081 | 5.12 × 105 | 3.31 × 109 |
| 1 × 106 | 51.60 | 6 | 5.05 | |||||
| 1 × 107 | 68.83 | 7 | 5.50 | |||||
| 1 × 108 | 77.34 | 8 | 5.74 | |||||
| PLPS8 | 1 × 105 | 48.21 | 5 | 4.95 | a = 0.345 b = 3.175 | Y = 0.345X + 3.175 | 1.99 × 105 | 9.39 × 108 |
| 1 × 106 | 55.27 | 6 | 5.13 | |||||
| 1 × 107 | 75.35 | 7 | 5.67 | |||||
| 1 × 108 | 81.58 | 8 | 5.92 | |||||
| PLMS9 | 1 × 105 | 48.21 | 5 | 4.72 | a = 0.287 b = 3.272 | Y = 0.287X + 3.272 | 1.04 × 106 | 3.01 × 1010 |
| 1 × 106 | 55.27 | 6 | 4.92 | |||||
| 1 × 107 | 75.35 | 7 | 5.39 | |||||
| 1 × 108 | 81.58 | 8 | 5.52 | |||||
| PLMC11 | 1 × 105 | 43.89 | 5 | 4.85 | a = 0.341 b = 3.121 | Y = 0.341X + 3.121 | 3.23 × 105 | 1.81 × 109 |
| 1 × 106 | 53.05 | 6 | 5.08 | |||||
| 1 × 107 | 73.18 | 7 | 5.61 | |||||
| 1 × 108 | 79.47 | 8 | 5.81 | |||||
| PLMS12 | 1 × 105 | 40.98 | 5 | 4.77 | a = 0.314 b = 3.194 | Y = 0.314X + 3.194 | 5.60 × 105 | 6.60 × 109 |
| 1 × 106 | 50.86 | 6 | 5.03 | |||||
| 1 × 107 | 68.09 | 7 | 5.47 | |||||
| 1 × 108 | 75.18 | 8 | 5.67 | |||||
| PLMS44 | 1 × 105 | 39.54 | 5 | 4.75 | a = 0.314 b = 3.159 | Y = 0.314X + 3.159 | 7.24 × 105 | 8.51 × 109 |
| 1 × 106 | 49.26 | 6 | 4.97 | |||||
| 1 × 107 | 66.62 | 7 | 5.44 | |||||
| 1 × 108 | 73.79 | 8 | 5.64 | |||||
| PLMS88 | 1 × 105 | 38.83 | 5 | 4.72 | a = 0.293 b = 3.324 | Y = 0.293X + 3.324 | 1.00 × 106 | 2.34 × 1010 |
| 1 × 106 | 47.79 | 6 | 4.95 | |||||
| 1 × 107 | 65.17 | 7 | 5.39 | |||||
| 1 × 108 | 71.46 | 8 | 5.55 | |||||
| PLMS113 | 1 × 105 | 41.82 | 5 | 4.80 | a = 0.338 b = 3.078 | Y = 0.338X + 3.078 | 4.78× 105 | 2.95 × 109 |
| 1 × 106 | 50.74 | 6 | 5.03 | |||||
| 1 × 107 | 69.54 | 7 | 5.50 | |||||
| 1 × 108 | 78.05 | 8 | 5.77 | |||||
| 1 × 105 | 50.35 | 5 | 5.00 | a = 0.347 b = 3.212 | Y = 0.347X + 3.212 | 1.41 × 105 | 6.91 × 108 | |
| GHA | 1 × 106 | 55.81 | 6 | 5.15 | ||||
| 1 × 107 | 77.54 | 7 | 5.77 | |||||
| 1 × 108 | 83.00 | 8 | 5.95 |
| Isolates | Mortality Time (Day) | Mortality (%) | Log10 of Mortality Time (Day) | Probit Mortality | Regression Statistics, a = slope b = intercept | Regression Equation, Y = aX + b | LT50 (in LT50 Calculation, Y = 5, LT50 = antilogX) (Day) | LT90 (in LT90 Calculation, Y = 6.28, LT90 = antilogX) (Day) |
|---|---|---|---|---|---|---|---|---|
| PLMS4 | 2 | 12.00 | 0.30 | 3.82 | a = 3.954 b = 2.630 | Y = 3.954 X + 2.630 | 3.97 | 8.37 |
| 3 | 28.85 | 0.48 | 4.42 | |||||
| 4 | 57.22 | 0.60 | 5.18 | |||||
| 5 | 65.01 | 0.70 | 5.39 | |||||
| 6 | 74.79 | 0.78 | 5.64 | |||||
| PLTP5 | 2 | 17.33 | 0.30 | 4.05 | a = 4.512 b = 2.638 | Y = 4.512 X + 2.638 | 3.16 | 6.30 |
| 3 | 36.91 | 0.48 | 4.67 | |||||
| 4 | 65.53 | 0.60 | 5.41 | |||||
| 5 | 79.70 | 0.70 | 5.84 | |||||
| 6 | 87.26 | 0.78 | 6.13 | |||||
| PLKM7 | 2 | 11.33 | 0.30 | 3.77 | a = 4.164 b = 2.544 | Y = 4.164 X + 2.544 | 3.89 | 7.76 |
| 3 | 30.87 | 0.48 | 4.50 | |||||
| 4 | 58.61 | 0.60 | 5.20 | |||||
| 5 | 66.40 | 0.70 | 5.41 | |||||
| 6 | 77.34 | 0.78 | 5.74 | |||||
| PLPS8 | 2 | 14.66 | 0.30 | 3.96 | a = 4.221 b = 2.653 | Y = 4.221 X + 2.653 | 3.55 | 7.24 |
| 3 | 32.88 | 0.48 | 4.56 | |||||
| 4 | 61.39 | 0.60 | 5.28 | |||||
| 5 | 72.69 | 0.70 | 5.61 | |||||
| 6 | 81.85 | 0.78 | 5.92 | |||||
| PLMS9 | 2 | 11.33 | 0.30 | 3.77 | a = 3.823 b = 2.636 | Y = 3.823 X + 2.636 | 4.14 | 8.97 |
| 3 | 27.51 | 0.48 | 4.39 | |||||
| 4 | 54.46 | 0.60 | 5.10 | |||||
| 5 | 62.91 | 0.70 | 5.33 | |||||
| 6 | 70.06 | 0.78 | 5.52 | |||||
| PLMC11 | 2 | 13.33 | 0.30 | 3.87 | a = 4.208 b = 2.587 | Y = 4.208 X + 2.587 | 3.71 | 7.58 |
| 3 | 30.87 | 0.48 | 4.50 | |||||
| 4 | 59.29 | 0.60 | 5.23 | |||||
| 5 | 70.59 | 0.70 | 5.55 | |||||
| 6 | 79.34 | 0.78 | 5.81 | |||||
| PLMS12 | 2 | 12.66 | 0.30 | 3.82 | a = 3.996 b = 2.622 | Y = 3.996 X + 2.622 | 3.93 | 8.22 |
| 3 | 29.53 | 0.48 | 4.45 | |||||
| 4 | 57.20 | 0.60 | 5.18 | |||||
| 5 | 65.70 | 0.70 | 5.41 | |||||
| 6 | 75.18 | 0.78 | 5.67 | |||||
| PLMS44 | 2 | 12.00 | 0.30 | 3.82 | a = 3.958 b = 2.631 | Y = 3.958 X + 2.631 | 3.96 | 8.33 |
| 3 | 28.19 | 0.48 | 4.42 | |||||
| 4 | 57.93 | 0.60 | 5.20 | |||||
| 5 | 65.05 | 0.70 | 5.39 | |||||
| 6 | 73.79 | 0.78 | 5.64 | |||||
| PLMS88 | 2 | 11.33 | 0.30 | 3.77 | a = 3.911 b = 2.614 | Y = 3.911 X + 2.614 | 4.07 | 8.64 |
| 3 | 27.52 | 0.48 | 4.39 | |||||
| 4 | 55.85 | 0.60 | 5.18 | |||||
| 5 | 63.67 | 0.70 | 5.36 | |||||
| 6 | 71.46 | 0.78 | 5.55 | |||||
| PLMS113 | 2 | 13.33 | 0.30 | 3.87 | a = 4.098 b = 2.625 | Y = 4.098X + 2.625 | 3.80 | 7.78 |
| 3 | 30.85 | 0.48 | 4.50 | |||||
| 4 | 58.61 | 0.60 | 5.20 | |||||
| 5 | 69.21 | 0.70 | 5.50 | |||||
| 6 | 78.05 | 0.78 | 5.77 | |||||
| GHA | 2 | 15.33 | 0.30 | 3.96 | a = 4.312 b = 2.653 | Y = 4.312 X + 2.653 | 3.54 | 6.91 |
| 3 | 35.56 | 0.48 | 4.64 | |||||
| 4 | 63.46 | 0.60 | 5.33 | |||||
| 5 | 75.55 | 0.70 | 5.71 | |||||
| 6 | 83.00 | 0.78 | 5.95 |
Publisher’s Note: MDPI stays neutral with regard to jurisdictional claims in published maps and institutional affiliations. |
© 2022 by the authors. Licensee MDPI, Basel, Switzerland. This article is an open access article distributed under the terms and conditions of the Creative Commons Attribution (CC BY) license (https://creativecommons.org/licenses/by/4.0/).
Share and Cite
Islam, M.S.; Subbiah, V.K.; Siddiquee, S. Field Efficacy of Proteolytic Entomopathogenic Fungi against Ceratovacuna lanigera Zehntner. Horticulturae 2022, 8, 808. https://doi.org/10.3390/horticulturae8090808
Islam MS, Subbiah VK, Siddiquee S. Field Efficacy of Proteolytic Entomopathogenic Fungi against Ceratovacuna lanigera Zehntner. Horticulturae. 2022; 8(9):808. https://doi.org/10.3390/horticulturae8090808
Chicago/Turabian StyleIslam, Md. Shafiqul, Vijay Kumar Subbiah, and Shafiquzzaman Siddiquee. 2022. "Field Efficacy of Proteolytic Entomopathogenic Fungi against Ceratovacuna lanigera Zehntner" Horticulturae 8, no. 9: 808. https://doi.org/10.3390/horticulturae8090808
APA StyleIslam, M. S., Subbiah, V. K., & Siddiquee, S. (2022). Field Efficacy of Proteolytic Entomopathogenic Fungi against Ceratovacuna lanigera Zehntner. Horticulturae, 8(9), 808. https://doi.org/10.3390/horticulturae8090808






